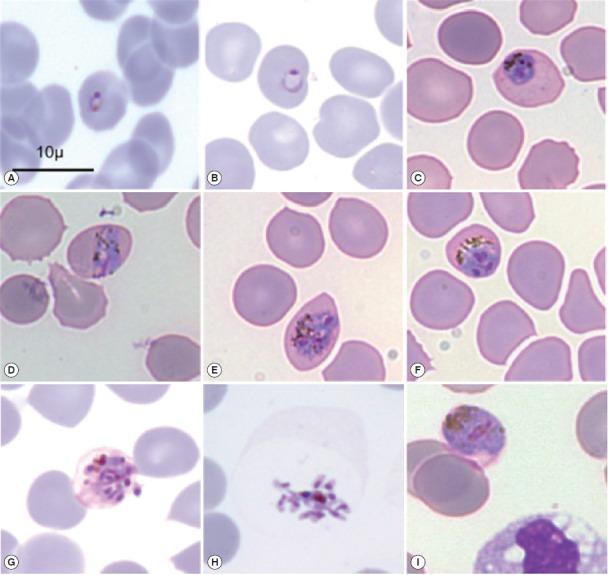
https://cdn.ncbi.nlm.nih.gov/pmc/blobs/1669/4635839/55d9b4dad338/kjp-53-5-575f2.jpg

诺氏疟原虫对全球公共卫生构成威胁。
Plasmodium knowlesi as a Threat to Global Public Health.
作者信息
Wesolowski Roland, Wozniak Alina, Mila-Kierzenkowska Celestyna, Szewczyk-Golec Karolina
机构信息
The Chair of Medical Biology, Ludwik Rydygier Collegium Medicum of Nicolaus Copernicus University, Bydgoszcz, Poland.
出版信息
Korean J Parasitol. 2015 Oct;53(5):575-81. doi: 10.3347/kjp.2015.53.5.575. Epub 2015 Oct 29.
Malaria is a tropical disease caused by protozoans of the Plasmodium genus. Delayed diagnosis and misdiagnosis are strongly associated with higher mortality. In recent years, a greater importance is attributed to Plasmodium knowlesi, a species found mainly in Southeast Asia. Routine parasitological diagnostics are associated with certain limitations and difficulties in unambiguous determination of the parasite species based only on microscopic image. Recently, molecular techniques have been increasingly used for predictive diagnosis. The aim of the study is to draw attention to the risk of travelling to knowlesi malaria endemic areas and to raise awareness among personnel involved in the therapeutic process.
疟疾是一种由疟原虫属原生动物引起的热带疾病。延迟诊断和误诊与较高的死亡率密切相关。近年来,诺氏疟原虫受到了更多关注,该物种主要在东南亚被发现。常规寄生虫学诊断存在一定局限性,仅基于显微镜图像明确确定寄生虫种类存在困难。最近,分子技术越来越多地用于预测性诊断。该研究的目的是提醒人们注意前往诺氏疟原虫疟疾流行地区旅行的风险,并提高参与治疗过程的人员的认识。